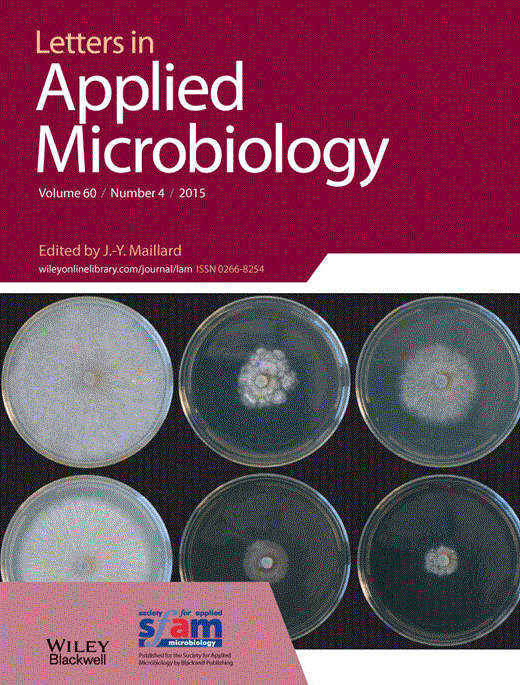

Publications

Biogeographic survey of soil bacterial communities across Antarctica.
Varliero, G., Lebre, P.H., Adams, B. et al. 2024. Biogeographic survey of soil bacterial communities across Antarctica. Microbiome 12, pp 9 . doi: 10.1186/s40168-023-01719-3
 Leveraging marine biotechnology for an All-Atlantic sustainable blue economy.
Leveraging marine biotechnology for an All-Atlantic sustainable blue economy.
Thompson C, Ortmann AC, Makhalanyane T, Thompson F. 2024. Leveraging marine biotechnology for an All-Atlantic sustainable blue economy. Trends in Biotechnology. doi:10.1016/j.tibtech.2023.12.011
 Hotspots of biogeochemical activity controlled by aridity and plant traits across global drylands.
Hotspots of biogeochemical activity controlled by aridity and plant traits across global drylands.
Eldridge, D.J., Ding, J., Dorrough, J. et al.2024. Hotspots of biogeochemical activity linked to aridity and plant traits across global drylands. Nat. Plants 10, pp 760–770. doi:10.1038/s41477-024-01670-7
 Urban greenspaces and nearby natural areas support similar levels of soil ecosystem services across a global range.
Urban greenspaces and nearby natural areas support similar levels of soil ecosystem services across a global range.
Eldridge, D.J., Cui, H., Ding, J. et al. 2024. Urban greenspaces and nearby natural areas support similar levels of soil ecosystem services. npj urban sustainability 4, pp15. doi:10.1038/s42949-024-00154-z
 A global atlas of soil viruses reveals unexplored biodiversity and potential biogeochemical impacts.
A global atlas of soil viruses reveals unexplored biodiversity and potential biogeochemical impacts.
Graham, E.B., Camargo, A.P., Wu, R. et al 2024. A global atlas of soil viruses reveals unexplored biodiversity and potential biogeochemical impacts. Nat Microbiol 9, 1873–1883. doi: 10.1038/s41564-024-01686-x
 Changes in nutrient availability substantially alter bacteria and extracellular enzymatic activities in Antarctic soils.
Changes in nutrient availability substantially alter bacteria and extracellular enzymatic activities in Antarctic soils.
Nair, G.R., Kooverjee, B.B., de Scally, S., Cowan, D.A., Makhalanyane, T.P. 2024 Changes in nutrient availability substantially alter bacteria and extracellular enzymatic activities in Antarctic soils. FEMS Microbiology Ecology 100, Issue 6, fiae071. doi: 10.1093/femsec/fiae071
 Harnessing Marine Microbiomes to Develop a Sustainable, All-Atlantic Bio economy.
Harnessing Marine Microbiomes to Develop a Sustainable, All-Atlantic Bio economy.
Thompson ,C., Ortmann, A.C., Bolhuis, H., Makhalanyane, T., Thompson, F. 2024. Harnessing marine microbiomes to develop a sustainable, all-Atlantic bioeconomy. mLife 3, pp 163–166. doi: 10.1002/mlf2.12124
 Phylogenomic analysis expands the known repertoire of single and double stranded DNA viruses in benthic zones of the South Indian Ocean.
Phylogenomic analysis expands the known repertoire of single and double stranded DNA viruses in benthic zones of the South Indian Ocean.
Bezuidt, O.K.I., Makhalanyane, T.P. 2024. Phylogenomic analysis expands the known repertoire of single-stranded DNA viruses in benthic zones of the South Indian Ocean. ISME Communications 4, Issue 1, ycae065. doi:10.1093/ismeco/ycae065
 Microbiome research in Africa must be based on equitable partnerships.
Microbiome research in Africa must be based on equitable partnerships.
Oduaran, O.H., Foláyan, M.O., Kamng’ona, A.W. et al. 2024. Microbiome research in Africa must be based on equitable partnerships. Nauret Medicine 30, pp 2715–2717. doi: 10.1038/s41591-024-03026-2
 Unearthing the soil-borne microbiome of land plants.
Unearthing the soil-borne microbiome of land plants.
Ochoa-Hueso, R., Eldridge, D. J., Berdugo, M., Trivedi, P., Sokoya, B., Cano-Díaz, C., Abades, S., Alfaro, F., Bamigboye, A. R., Bastida, F., Blanco-Pastor, J. L., de los Rios, A., Durán, J., Geisen, S., Grebenc, T., Illán, J. G., Liu, Y.-R., Makhalanyane, T. P., Mamet, S., … Delgado-Baquerizo, M. 2024. Unearthing the soil-borne microbiome of land plants. Global Change Biology, 30, e17295. doi:10.1111/gcb.17295
 A concept for international societally relevant microbiology education and microbiology knowledge promulgation in society.
A concept for international societally relevant microbiology education and microbiology knowledge promulgation in society.
Timmis, K., Hallsworth, J.E., McGenity, T.J., Armstrong, R., Colom, M.F., Karahan, Z.C., Chavarría, M., Bernal, P., Boyd, E.S., Ramos, J.L., Kaltenpoth, M., Pruzzo, C., Clarke, G., López-Garcia, P., Yakimov, M.M., Perlmutter, J., Greening, C., Eloe-Fadrosh, E., Verstraete, W., Nunes, O.C., Kotsyurbenko, O., Nikel, P.I., Scavone, P., Häggblom, M.M., Lavigne, R., Le Roux, F., Timmis, J.K., Parro, V., Michán, C., García, J.L., Casadevall, A., Payne, S.M., Frey, J., Koren, O., Prosser, J.I., Lahti, L., Lal, R., Anand, S., Sood, U., Offre, P., Bryce, C.C., Mswaka, A.Y., Jores, J., Kaçar, B., Blank, L.M., Maaßen, N., Pope, P.B., Banciu, H.L., Armitage, J., Lee, S.Y., Wang, F., Makhalanyane, T.P., Gilbert, J.A., Wood, T.K., Vasiljevic, B., Soberón, M., Udaondo, Z., Rojo, F., Tamang, J.P., Giraud, T., Ropars, J., Ezeji, T., Müller, V., Danbara, H., Averhoff, B., Sessitsch, A., Partida-Martínez, L.P., Huang, W., Molin, S., Junier, P., Amils, R., Wu, X.-L., Ron, E., Erten, H., de Martinis, E.C.P., Rapoport, A., Öpik, M., Pokatong, W.D.R., Stairs, C., Amoozegar, M.A., Serna, J.G. 2024. A concept for international societally relevant microbiology education and microbiology knowledge promulgation in society. Microbial Biotechnology 17: e14456. doi:10.1111/1751-7915.14456
 Unforeseen plant phenotypic diversity in a dry and grazed world.
Unforeseen plant phenotypic diversity in a dry and grazed world.
Gross, N., Maestre, F.T., Liancourt, P. et al. 2024. Unforeseen plant phenotypic diversity in a dry and grazed world. Nature 632, pp 808–814. doi:10.1038/s41586-024-07731-3
 Vulnerability of mineral-protected soil organic carbon to climate in global drylands.
Vulnerability of mineral-protected soil organic carbon to climate in global drylands.
Díaz-Martínez, P., Maestre, F.T., Moreno-Jiménez, E. et al. 2024. Vulnerability of mineral-associated soil organic carbon to climate across global drylands. Nature Climate Change 14, pp 976–982. doi: 10.1038/s41558-024-02087-y
 Clarifying the healthy microbiome concept through an epidemiological lens.
Clarifying the healthy microbiome concept through an epidemiological lens.
Joos, R., Boucher, K., Lavelle, A. et al. 2024. Examining the healthy human microbiome concept. Nature Reviews Microbiology. doi:10.1038/s41579-024-01107-0
 Microbial solutions must be deployed against climate catastrophe.
Microbial solutions must be deployed against climate catastrophe.
Peixoto, R., Voolstra, C.R., Stein, L.Y. et al. 2024. Microbial solutions must be deployed against climate catastrophe. Nature Communications 15, pp 9637. doi: 10.1038/s41467-024-53680-w
 Synergizing ecotoxicology and microbiome data is key for developing global indicators of environmental antimicrobial resistance.
Synergizing ecotoxicology and microbiome data is key for developing global indicators of environmental antimicrobial resistance.
John Makumbi, Samuel Leareng, Rian Pierneef, Thulani P. Makhalanyane. Synergizing ecotoxicology and microbiome data is key for developing global indicators of environmental antimicrobial resistance. Microbial Ecology 87, 150. doi:10.1007/s00248-024-02463-3
 Soil biodiversity supports the delivery of multiple ecosystem functions in urban greenspaces.
Soil biodiversity supports the delivery of multiple ecosystem functions in urban greenspaces.
Fan, K., Chu, H., Eldridge, D.J. et al. 2023. Soil biodiversity supports the delivery of multiple ecosystem functions in urban greenspaces. Nature Ecology and Evolution 7, pp 113–126. doi:10.1038/s41559-022-01935-4
 CrAssphage may be viable markers of contamination in pristine and contaminated river water.
CrAssphage may be viable markers of contamination in pristine and contaminated river water.
Mafumo, N., Bezuidt, O.K.I., le Roux, W., Makhalanyane, T.P. 2023. CrAssphage May Be Viable Markers of Contamination in Pristine and Contaminated River Water. mSystems 8:e01282-22. doi:10.1128/msystems.01282-22
 Metagenome assembled genomes of four Southern Ocean archaea which harbour multiple genes linked to polyethylene terephthalate.
Metagenome assembled genomes of four Southern Ocean archaea which harbour multiple genes linked to polyethylene terephthalate.
Akpudo, Y.M., Bezuidt, O.K.I., Makhalanyane, T.P. 2023. Metagenome-Assembled Genomes of Four Southern Ocean Archaea Harbor Multiple Genes Linked to Polyethylene Terephthalate and Polyhydroxybutyrate Plastic Degradation. Microbiology Resource Announcements 12:e01098-22. doi:10.1128/mra.01098-22.
 The use of different 16S rRNA gene variable regions in biogeographical studies.
The use of different 16S rRNA gene variable regions in biogeographical studies.
Varliero, G., Lebre, P.H., Stevens, M.I., Czechowski, P., Makhalanyane, T.P, Cowan, D.A. 2023. The use of different 16S rRNA gene variable regions in biogeographical studies. Environmental Microbiology Reports, 15(3), pp 216–228. doi:10.1111/1758-2229.13145
 Biogenic factors explain soil carbon in paired urban and natural ecosystems worldwide.
Biogenic factors explain soil carbon in paired urban and natural ecosystems worldwide.
Delgado-Baquerizo, M., García-Palacios, P., Bradford, M.A. et al. 2023. Biogenic factors explain soil carbon in paired urban and natural ecosystems worldwide. Nature Climate Change 13, pp 450–455. doi: 10.1038/s41558-023-01646-z
 Soil contamination in nearby natural areas mirrors that in urban greenspaces worldwide.
Soil contamination in nearby natural areas mirrors that in urban greenspaces worldwide.
Liu, YR., van der Heijden, M.G.A., Riedo, J. et al. 2023. Soil contamination in nearby natural areas mirrors that in urban greenspaces worldwide. Nature Communications 14, pp 1706. doi: 10.1038/s41467-023-37428-6
 The global contribution of soil mosses to ecosystem services.
The global contribution of soil mosses to ecosystem services.
Eldridge, D.J., Guirado, E., Reich, P.B. et al. 2023. The global contribution of soil mosses to ecosystem services. Nature Geoscience 16, pp 430–438. doi:10.1038/s41561-023-01170-x
 Bacteria and Archaea Regulate Particulate Organic Matter Export in Suspended and Sinking Marine Particle Fractions.
Bacteria and Archaea Regulate Particulate Organic Matter Export in Suspended and Sinking Marine Particle Fractions.
Dithugoe, C.D., Bezuidt, O.K.I., Cavan, E.L., Froneman, W.P., Thomalla, S.J., Makhalanyane, T.P. 2023. Bacteria and Archaea Regulate Particulate Organic Matter Export in Suspended and Sinking Marine Particle Fractions. mSphere 8:e00420-22. doi: 10.1128/msphere.00420-22
 African Microbiomes Matter.
African Microbiomes Matter.
Makhalanyane, T.P., Bezuidt, O.K.I., Pierneef, R.E. et al. 2023. African microbiomes matter. Nature Reviews Microbiology 21, pp 479–481. doi: 10.1038/s41579-023-00925-y
 Illuminating microbial defense systems in extreme environments.
Illuminating microbial defense systems in extreme environments.
Makhalanyane, T.P. 2023. Illuminating microbial defence systems in extreme environments. Nature Reviews Microbiology 21, pp 636. doi:10.1038/s41579-023-00956-5
 Catalyzing progress in the blue economy through joint marine microbiome research across the Atlantic.
Catalyzing progress in the blue economy through joint marine microbiome research across the Atlantic.
Ortmann, A.C., Goodwin, K.D., Bolhuis, H., Groben, R., Makhalanyane, T.P., Bowman, J., Robinson, S., Thompson, F. 2023. Catalyzing progress in the blue economy through joint marine microbiome research across the Atlantic. Frontiers in Marine Science 10. doi:10.3389/fmars.2023.1327719
 Polar soils exhibit distinct patterns in microbial diversity and dominant phylotypes.
Polar soils exhibit distinct patterns in microbial diversity and dominant phylotypes.
Ji, M., Kong, W., Jia, H., Delgado-Baquerizo, M., Zhou, T., Liu, X., Ferrari, B.C., Malard, L., Liang, C., Xue, K., Makhalanyane, T.P., Zhu,Y-G., Wang, Y., Pearce, D.A., Cowan, D. 2022. Polar soils exhibit distinct patterns in microbial diversity and dominant phylotypes. Soil Biology and Biochemistry 166, 108550. doi:10.1016/j.soilbio.2022.108550
 Four Lentisphaerae family metagenome assembled genomes from the South Atlantic Ocean.
Four Lentisphaerae family metagenome assembled genomes from the South Atlantic Ocean.
Makinde, O.A., Lunga, P.M., Bezuidt, O.K.I., Makhalanyane, T.P. 2022. Four Lentisphaerae Family Metagenome-Assembled Genomes from the South Atlantic Ocean. Microbial Resource Announcements 11:e00496-22. Doi: 10.1128/mra.00496-22
 Biogeographical survey of soil microbiomes across sub-Saharan Africa: structure, drivers, and predicted climate-driven changes.
Biogeographical survey of soil microbiomes across sub-Saharan Africa: structure, drivers, and predicted climate-driven changes.
Cowan, D., Lebre, P., Amon, C. et al. 2022. Biogeographical survey of soil microbiomes across sub-Saharan Africa: structure, drivers, and predicted climate-driven changes. Microbiome 10, pp13. doi: 10.1186/s40168-022-01297-w
 Global hotspots for soil nature conservation.
Global hotspots for soil nature conservation.
Guerra, C.A., Berdugo, M., Eldridge, D.J. et al. 2022. Global hotspots for soil nature conservation. Nature 610, pp 693–698. doi: 10.1038/s41586-022-05292-x
 Microbiome ethics, guiding principles for microbiome research, use and knowledge management.
Microbiome ethics, guiding principles for microbiome research, use and knowledge management.
Lange, L., Berg, G., Cernava, T. et al. 2022. Microbiome ethics, guiding principles for microbiome research, use and knowledge management. Environmental Microbiome 17, pp 50. doi: 10.1186/s40793-022-00444-y
 Microbial ecology of the Southern Ocean.
Microbial ecology of the Southern Ocean.
Castillo, D.J., Dithugoe, C.D., Bezuidt, O.K.I, Makhalanyane, T.P. 2022. Microbial ecology of the Southern Ocean. FEMS Microbiology Ecology 98, Issue 11, fiac123. doi:10.1093/femsec/fiac123
 Draft Whole-Genome Sequence of Penicillium simplicissimum A4, a Putative Endophyte from Echium plantagineum.
Draft Whole-Genome Sequence of Penicillium simplicissimum A4, a Putative Endophyte from Echium plantagineum.
Fisher, S., De Villers, D., Du Plessis, M., Hattingh, K., Saulse, C., Basson, G., Barker, A., Innalegwu Daniel, A., Al-Hashimi, A., Hitzeroth, A., Makhalanyane, T.P, Mavumengwana, V., Gokul, A., Keyster, M., Klein, A. 2022. Draft Whole-Genome Sequence of Penicillium simplicissimum A4, a Putative Endophyte from Echium plantagineum. Microbiology Resource Announcements 11:e00854-22. doi:10.1128/mra.00854-22
 Dysbiosis and immune dysregulation: distilling the evidence.
Dysbiosis and immune dysregulation: distilling the evidence.
Rossouw, T.M., Makhalanyane, T.P. 2022. Dysbiosis and immune dysregulation: distilling the evidence. AIDS 36, Issue 14, pp 2065-2066. doi:10.1097/QAD.0000000000003380
 The global distribution and environmental drivers of the soil antibiotic resistome.
The global distribution and environmental drivers of the soil antibiotic resistome.
Delgado-Baquerizo, M., Hu, H.W., Maestre, F.T. et al. 2022. The global distribution and environmental drivers of the soil antibiotic resistome. Microbiome 10, 219, doi: 10.1186/s40168-022-01405-w
 Grazing and ecosystem service delivery in global drylands.
Grazing and ecosystem service delivery in global drylands.
Fernando T. Maestre et al. 2022. Grazing and ecosystem service delivery in global drylands. Science 378, pp 915-920. doi:10.1126/science.abq4062
 Standardized multi-omics of Earth’s microbiomes reveals microbial and metabolite diversity.
Standardized multi-omics of Earth’s microbiomes reveals microbial and metabolite diversity.
Shaffer, J.P., Nothias, L.F., Thompson, L.R. et al. 2022. Standardized multi-omics of Earth’s microbiomes reveals microbial and metabolite diversity. Nature Microbiology 7, pp 2128–2150. doi:10.1038/s41564-022-01266-x
 Dissolved inorganic carbon offsets salinity constraints on primary production in lakes.
Dissolved inorganic carbon offsets salinity constraints on primary production in lakes.
Yue, L., Kong, W., Li, C., Zhu, G., Zhu, L., Makhalanyane, T.P., Cowan, D.A. 2021, Dissolved inorganic carbon determines the abundance of microbial primary producers and primary production in Tibetan Plateau lakes. FEMS Microbiol Ecol. 2021 Jan 26;97(2):fiaa242. doi: 10.1093/femsec/fiaa242. Erratum in: FEMS Microbiol Ecology 28;97(10):fiab133. doi:10.1093/femsec/fiab133. PMID: 33242086.
 The composition of antibiotic resistance genes is not affected by grazing but is determined by microorganisms in grassland soils.
The composition of antibiotic resistance genes is not affected by grazing but is determined by microorganisms in grassland soils.
Zheng, Z., Li, L., Makhalanyane, T.P., Xu, C., Li, K., Xue, K., Xu, C., Qian, R., Zhang, B., Du, J., Yu, H., Cui, X., Wang, Y., Hao, Y. 2021. The composition of antibiotic resistance genes is not affected by grazing but is determined by microorganisms in grassland soils. Science of The Total Environment 761, 143205. doi:10.1016/j.scitotenv.2020.143205
 Depth-dependent variables shape community structure and functionality in the Prince Edward Islands.
Depth-dependent variables shape community structure and functionality in the Prince Edward Islands.
Phoma, B.S., Makhalanyane, T.P. 2021. Depth-Dependent Variables Shape Community Structure and Functionality in the Prince Edward Islands. Microbial Ecoogyl 81, pp 396–409. doi:10.1007/s00248-020-01589-4
 Islands in the sand: Are all hypolithic microbial communities the same?
Islands in the sand: Are all hypolithic microbial communities the same?
Lebre, P., Bottos, E., Makhalanyane, T.P., Hogg, I., D.A. Cowan. 2021. Islands in the sand: Are all hypolithic microbial communities the same? FEMS Microbiology Ecology. doi:10.1093/femsec/fiaa216
 Pathogen infection selects a distinct microbial community in sorghum RILs.
Pathogen infection selects a distinct microbial community in sorghum RILs.
Masenya, K., Thompson, G.D., Tekere, M., Makhalanyane, T.P., Pierneef, R.E., Rees, D.J.G. 2021Pathogen infection influences a distinct microbial community composition in sorghum RILs. Plant and Soil. 463, pp 555–572. doi:10.1007/s11104-021-04875-3
 Shotgun metagenomics reveals distinct functional diversity and metabolic capabilities between 12 000 year old permafrost and active layers on Muot da Barba Peider (Swiss Alps).
Shotgun metagenomics reveals distinct functional diversity and metabolic capabilities between 12 000 year old permafrost and active layers on Muot da Barba Peider (Swiss Alps).
Perez, C., Weihong, Q., Vikram, S., Frossard, A., Makhalanyane, T.P., Cowan, D.A. and B. Frey. 2021. Shotgun metagenomics reveals distinct functional diversity and metabolic capabilities between 12 000 year old permafrost and active layers on Muot da Barba Peider (Swiss Alps). Microbial Genomics. doi:10.1099/mgen.0.000558
 Global homogenization of the structure and function in the soil microbiome of urban greenspaces.
Global homogenization of the structure and function in the soil microbiome of urban greenspaces.
Delgado-Baquerizo, M., et al. 2021. Global homogenization of the structure and function in the soil microbiome of urban greenspaces. Science Advances 7,eabg5809. doi:10.1126/sciadv.abg5809
 Microbial anhydrobiosis.
Microbial anhydrobiosis.
Bosch, J., Varliero, G., Hallsworth, J.E., Dallas, T.D., Hopkins, D., Frey, B., Kong, W., Lebre, P., Makhalanyane, T.P. and Cowan, D.A. 2021. Microbial anhydrobiosis. Environmental Microbiology 23, pp 6377-6390. Doi:10.1111/1462-2920.15699
 Three Draft Single-Cell Genomes of Novel SAR324 Strains Isolated from the Abyssopelagic Southern Ocean.
Three Draft Single-Cell Genomes of Novel SAR324 Strains Isolated from the Abyssopelagic Southern Ocean.
Castillo, D.J., Van Goethem, M.W., Makhalanyane, T.P. 2021. Three Draft Single-Cell Genome Sequences of Novel SAR324 Strains Isolated from the Abyssopelagic Southern Ocean. Microbial Resource Announcements 30;10(39):e0075921. doi:10.1128/MRA.00759-21.
 Multiple energy sources and metabolic strategies sustain microbial diversity in Antarctic desert soils.
Multiple energy sources and metabolic strategies sustain microbial diversity in Antarctic desert soils.
Ortiz, M., Leung, P.M., Shelley, G., Jirapanjawat, T., Nauer, P.A., Van Goethem, M.W., Bay, S.K., Islam, Z.F., Jordaan, K., Vikram, S., Chown, S.L., Hogg, I.D., Makhalanyane, T.P., Grinter, R., Cowan, D.A., Greening, C. 2021. Multiple energy sources and metabolic strategies sustain microbial diversity in Antarctic desert soils, Proceedings of the National Academy of Sciences 118 (45) e2025322118. doi: 10.1073/pnas.2025322118
 Long-read metagenomics of soil communities reveals phylum-specific secondary metabolite dynamics.
Long-read metagenomics of soil communities reveals phylum-specific secondary metabolite dynamics.
Van Goethem, M.W., Osborn, A.R., Bowen, B.P. et al. 2021. Long-read metagenomics of soil communities reveals phylum-specific secondary metabolite dynamics. Communications Biology 4, pp1302. doi: 10.1038/s42003-021-02809-4
 Increased temperatures alter viable microbial biomass, ammonia oxidizing bacteria and extracellular enzymatic activities in Antarctic soils.
Increased temperatures alter viable microbial biomass, ammonia oxidizing bacteria and extracellular enzymatic activities in Antarctic soils.
Barnard, S., Van Goethem, M.W., de Scally, S.Z., Cowan, D.A., Jansen van Rensburg, P., Claassens, S., Makhalanyane, T.P. 2020. Increased temperatures alter viable microbial biomass, ammonia oxidizing bacteria and extracellular enzymatic activities in Antarctic soils. FEMS Microbiology Ecology. doi:10.1093/femsec/fiaa065
 Roadmap for naming uncultivated Archaea and Bacteria.
Roadmap for naming uncultivated Archaea and Bacteria.
Murray, A.E., Freudenstein, J., Gribaldo, S. et al. 2020. Roadmap for naming uncultivated Archaea and Bacteria. Nature Microbiology 5, pp 987–994. doi: 10.1038/s41564-020-0733-x
 Phages actively challenge niche communities in the Antarctic soils.
Phages actively challenge niche communities in the Antarctic soils.
Bezuidt, O.K., Lebre, P.H., Pierneef, R., León-Sobrino, C., Adriaenssens, E.M., Cowan, D.A., Van de Peer, Y., Makhalanyane, T.P . 2020. Phages actively challenge niche communities in the Antarctic soils. mSystems. 5. doi:10.1128/mSystems.00234-20.
 The gut mycobiota of rural and urban individuals is shaped by geography.
The gut mycobiota of rural and urban individuals is shaped by geography.
Kabwe, M.K., Vikram, S., Mulaudzi, K., Jansson, J.K., Makhalanyane, T.P 2020. The gut mycobiota of rural and urban individuals is shaped by geography. BMC Microbiology 20, pp 257. doi:10.1186/s12866-020-01907-3
 Microbial nitrogen cycling in Antarctic soils.
Microbial nitrogen cycling in Antarctic soils.
Ortiz, M., Bosch, J., Coclet, C., Johnson, J., Lebre, P., Salawu-Rotimi, A., Vikram, S., Makhalanyane, T.P., Cowan, D.A. 2020. Microbial nitrogen cycling in Antarctic soils. Microorganisms. 8(9), 1442. doi:10.3390/microorganisms8091442
 The functional potential of the rhizospheric microbiome of an invasive tree species, Acacia dealbata.
The functional potential of the rhizospheric microbiome of an invasive tree species, Acacia dealbata.
Kamutando, C.N., Vikram, S., Kamgan, G., Makhalanyane, T.P., Greve, M., Le Roux, J.J., Richardson, D.M., Cowan, D.A., Valverde, A. 2018. The functional potential of the rhizospheric microbiome of an invasive tree species, Acacia dealbata. Microbial Ecology. doi:10.1007/s00248-018-1214-0
 Structural characterization and directed evolution of a novel acetyl xylan esterase reveals thermostability determinants of the Carbohydrate Esterase 7 family.
Structural characterization and directed evolution of a novel acetyl xylan esterase reveals thermostability determinants of the Carbohydrate Esterase 7 family.
Adesioye, F.A., Makhalanyane, T.P., Vikram, S., Sewell, B.T., Schubert, W-D., Cowan, D.A. 2018. Structural characterization and directed evolution of a novel acetyl xylan esterase reveals thermostability determinants of the Carbohydrate Esterase 7 family. Applied and Environmental Microbiology 84:e02695-17. doi:1128/AEM.02695-17
 A reservoir of ‘historical’ antibiotic resistance genes in remote pristine Antarctic soils.
A reservoir of ‘historical’ antibiotic resistance genes in remote pristine Antarctic soils.
Van Goethem, M.W., Pierneef, R., Bezuidt, O.K.I., Van De Peer, Y., Cowan, D.A., Makhalanyane, T.P. 2018. A reservoir of ‘historical’ antibiotic resistance genes in remote pristine Antarctic soils. Microbiome 6, pp 40. doi:10.1186/s40168-018-0424-5
 The Agulhas current shapes microbial diversity and functionality.
The Agulhas current shapes microbial diversity and functionality.
Phoma, S., Vikram, S., Jansson, J.K., Ansorge, I.J., Cowan, D.A., Van De Peer, Y., Makhalanyane, T.P. 2018. The Agulhas current shapes microbial diversity and functionality. Scientific Reports 8, pp 10542 doi:10.1038/s41598-018-28939-0
 Draft genome sequence of Massilia sp. KIM isolated from the grassland biome soil in South Africa.
Draft genome sequence of Massilia sp. KIM isolated from the grassland biome soil in South Africa.
Vikram, S., Govinder, N., Kabwe, M.H., Bezuidt, O., Makhalanyane, T.P. 2017. Draft genome sequence of Massilia sp. KIM isolated from the grassland biome soil in South Africa. Genomics Data. 13, pp 24-26. doi:10.1016/j.gdata.2017.06.002.
 The draft genome sequence of Hymenobacter sp. CRA2 isolated from Nama Karoo shrub land soils from South Africa.
The draft genome sequence of Hymenobacter sp. CRA2 isolated from Nama Karoo shrub land soils from South Africa.
Kabwe, M.H., Govinder, N., Vikram, S., Bezuidt, O., Makhalanyane, T.P. 2017. The draft genome sequence of Hymenobacter sp. CRA2 isolated from Nama Karoo shrub land soils from South Africa. Genomics Data.13, pp 21-23. doi:10.1016/j.gdata.2017.06.001.
 Soil nutritional status and biogeography influence rhizosphere microbial communities associated with the invasive tree Acacia dealbata.
Soil nutritional status and biogeography influence rhizosphere microbial communities associated with the invasive tree Acacia dealbata.
Kamutando, C.N., Vikram, S., Kamgan-Nkuekam, G., Makhalanyane, T.P., Greve, M., Le Roux, J.J., Richardson, D.M., Cowan, D.A., Valverde, A. 2017. Soil nutritional status and biogeography influence rhizosphere microbial communities associated with the invasive tree Acacia dealbata. Scientific Reports 7, 6472. doi:10.1038/s41598-017-07018-w
 Environmental drivers of viral community composition in Antarctic soils identified by viromics.
Environmental drivers of viral community composition in Antarctic soils identified by viromics.
Adriaenssens, E.M., Kramer, R., Van Goethem, M.W., Makhalanyane, T.P., Hogg, I., Cowan, D.A. 2017. Environmental drivers of viral community composition in Antarctic soils identified by viromics. Microbiome 5, 83. doi:10.1186/s40168-017-0301-7
 Assembling metagenomes, one community at a time.
Assembling metagenomes, one community at a time.
van der Walt, A., Van Goethem, M.W., Ramond, J-B., Makhalanyane, T.P., Reva, O., Cowan, D.A. 2017. Assembling metagenomes, one community at a time. BMC Genomics. 18(1), pp 521. doi:10.1186/s12864-017-3918-9.
 Evidence of microbial rhodopsins in Antarctic Dry Valley edaphic systems.
Evidence of microbial rhodopsins in Antarctic Dry Valley edaphic systems.
Guerrero, L.D., Vikram, S., Makhalanyane, T.P., Cowan, D.A. 2017. Evidence of microbial rhodopsins in Antarctic Dry Valley edaphic systems. Environmental Microbiology. 19(9), pp 3755-3767. doi:10.1111/1462-2920.13877.
 Cyanobacteria and Alphaproteobacteria may facilitate cooperative interactions in niche communities.
Cyanobacteria and Alphaproteobacteria may facilitate cooperative interactions in niche communities.
Van Goethem, M.W., Makhalanyane, T.P. , Cowan, D.A., Valverde, A. 2017. Cyanobacteria and Alphaproteobacteria may facilitate cooperative interactions in niche communities. Frontiers in Microbiology. doi:10.3389/fmicb.2017.02099.
 Energy from thin air.
Energy from thin air.
Cowan, D.A., P. Makhalanyane. 2017. Energy from thin air. Nature. 552(7685), pp 336-337. doi:10.1038/d41586-017-07579-w.
 Microbial diversity and functional capacity in polar soils.
Microbial diversity and functional capacity in polar soils.
Makhalanyane, T.P., Van Goethem, M.W., Cowan, D.A. 2016. Microbial diversity and functional capacity in polar soils. Current Opinion in Biotechnology, 38, 159-166 doi:10.1016/j.copbio.2016.01.011.
 Metagenomic analysis provides insights into functional capacity in a hyperarid desert soil niche community.
Metagenomic analysis provides insights into functional capacity in a hyperarid desert soil niche community.
Vikram, S., Guerrero, L., Makhalanyane, T.P., Le, P., Seely, M., Cowan, D.A. 2016. Metagenomic analysis provides insights into functional capacity in a hyperarid desert soil niche community. Environmental Microbiology. 18(6), pp 1875-1888. doi:10.1111/1462-2920.13088
 Characterization of bacterial communities in lithobionts and soil niches from Victoria Valley, Antarctica.
Characterization of bacterial communities in lithobionts and soil niches from Victoria Valley, Antarctica.
Van Goethem, M.W., Makhalanyane, T.P., Valverde, A., Cary, S.C., Cowan, D.A. 2016. Characterization of bacterial communities in lithobionts and soil niches from Victoria Valley, Antarctica. FEMS Microbiology Ecology 92(4): fiw051. doi:10.1093/femsec/fiw051
 The Geobacillus pan-genome: implications for the evolution of the genus.
The Geobacillus pan-genome: implications for the evolution of the genus.
Bezuidt, O.K.I., Pierneef, R., Gomri, A.M., Adesioye, F., Makhalanyane, T.P., Kharroub, K., Cowan, D.A. 2016. The Geobacillus pan-genome: implications for the evolution of the genus. Frontiers in Microbiology 7, pp 723. doi:10.3389/fmicb.2016.00723
 Plants of the Fynbos biome harbour host species-specific bacterial communities.
Plants of the Fynbos biome harbour host species-specific bacterial communities.
Miyambo, T., Makhalanyane, T.P., Cowan, D.A., Valverde, A. 2016. Plants of the Fynbos biome harbour host species-specific bacterial communities. FEMS Microbiology Letters 363(15) pii: fnw122. doi:10.1093/femsle/fnw122.
 Phylogeny, classification, and function of acetyl xylan esterases.
Phylogeny, classification, and function of acetyl xylan esterases.
Adesioye, F.A., Makhalanyane, T.P., Biely, P., Cowan, D.A. 2016. Phylogeny, classification, and function of acetyl xylan esterases. Enzyme and Microbial Technology 93-94, pp 79-91 doi:10.1016/j.enzmictec.2016.07.001
 Comparative metagenomic analysis reveals mechanisms for stress response in hypoliths from extreme hyperarid deserts.
Comparative metagenomic analysis reveals mechanisms for stress response in hypoliths from extreme hyperarid deserts.
Le, P., Makhalanyane, T.P., Guerrero, L., Vikram, S., Van de Peer, Y., Cowan, D.A. 2016. Comparative metagenomic analysis reveals mechanisms for stress response in hypoliths from extreme hyperarid deserts. Genome Biology and Evolution 8(9), pp 2737-2747. doi:10.1093/gbe/evw189.
 Antarctic microbial communities are functionally redundant, resistant and resilient to short term temperature perturbations.
Antarctic microbial communities are functionally redundant, resistant and resilient to short term temperature perturbations.
de Scally, S.Z., Makhalanyane, T.P., Frossard, A., Hogg, I., and Cowan, D.A. 2016. Antarctic microbial communities are functionally redundant, resistant and resilient to short term temperature perturbations. Soil Biology and Biochemistry 103, pp 160-170. doi:10.1016/j.soilbio.2016.08.013
 Draft genome sequence of Thermoactinomyces strain AS95 isolated from Thamelaht Sebkha, Algeria.
Draft genome sequence of Thermoactinomyces strain AS95 isolated from Thamelaht Sebkha, Algeria.
Bezuidt, O.K.I., Gomri, A.M., Pierneed, R., Van Goethem, M.W., Kharroub, K., Cowan, D.A., Makhalanyane, T.P. 2016. Draft genome sequence of Thermoactinomyces strain AS95 isolated from Thamelaht Sebkha, Algeria. Standards in Genomics Science. 11(1):68. doi:10.1186/s40793-016-0186-2.
 Temporal dynamics of hot desert microbial communities reveal structural and functional responses to water input.
Temporal dynamics of hot desert microbial communities reveal structural and functional responses to water input.
Armstrong, A., Valverde, A., Ramond, J-B., Makhalanyane, T.P., Jansson, J.K., Hopkins, D.A., Seely, M., Trindade, M., Cowan, D.A. 2016. Temporal dynamics of hot desert microbial communities reveal structural and functional responses to water input. Scientific Reports 6, 34434. doi:10.1038/srep34434.
 Normalization of environmental metagenomic DNA enhances the discovery of under-represented microbial community members.
Normalization of environmental metagenomic DNA enhances the discovery of under-represented microbial community members.
Ramond, J-B, Makhalanyane, T.P., Tuffin, M.I., Cowan, D.A. 2015. Normalization of environmental metagenomic DNA enhances the discovery of under-represented microbial community members. Letters in Applied Microbiology, 60(4), pp 359-366. doi:10.1111/lam.12380.
 Draft genome Sequence of Sphingomonas strain Ant20, isolated from oil-contaminated soil on Ross Island, Antarctica.
Draft genome Sequence of Sphingomonas strain Ant20, isolated from oil-contaminated soil on Ross Island, Antarctica.
Ronca, S., Frossard, A., Guerrero, L.D., Makhalanyane, T.P., Aislabie, J.M. Cowan, D.A. 2015. Draft genome Sequence of Sphingomonas strain Ant20, isolated from oil-contaminated soil on Ross Island, Antarctica. Genome Announcements, 3(1): e01309-14. doi:10.1128/genomeA.01309-14.
 Cyanobacteria drive community composition and functionality in rock-soil interface communities.
Cyanobacteria drive community composition and functionality in rock-soil interface communities.
Valverde, A, Makhalanyane, T.P., Seely, M., Cowan, D.A. 2015. Cyanobacteria drive community composition and functionality in rock-soil interface communities. Molecular Ecology, 24(4), pp 812-821. doi:10.1111/mec.13068.
 Microbial Ecology of hot desert edaphic systems.
Microbial Ecology of hot desert edaphic systems.
Makhalanyane, T.P., Valverde, A., Gunnigle, E., Frossard, A., Ramond, J-B, Cowan D.A. 2015. Microbial Ecology of hot desert edaphic systems. FEMS Microbiology Reviews, 39(2), pp 203-221. doi:10.1093/femsre/fuu011
 Ecology and biogeochemistry of cyanobacteria in soils, permafrost, aquatic and cryptic polar habitats.
Ecology and biogeochemistry of cyanobacteria in soils, permafrost, aquatic and cryptic polar habitats.
Makhalanyane, T.P., Valverde, A., Velázquez, D. et al. 2015. Ecology and biogeochemistry of cyanobacteria in soils, permafrost, aquatic and cryptic polar habitats. Biodiversity and Conservation 24, pp 819–840. doi: 10.1007/s10531-015-0902-z
 Draft genomic DNA sequence of the multi-resistant Sphingomonas strain AntH11 isolated from an Antarctic hypolith.
Draft genomic DNA sequence of the multi-resistant Sphingomonas strain AntH11 isolated from an Antarctic hypolith.
Gunnigle, E., Ramond, J-B., Guerrero, L., Makhalanyane, T.P., Cowan, D.A. 2015. Draft genomic DNA sequence of the multi-resistant Sphingomonas strain AntH11 isolated from an Antarctic hypolith. FEMS Microbiology Letters, 362(8), fnv037. doi:10.1093/femsle/fnv037
 Metagenomics of extreme environments.
Metagenomics of extreme environments.
Cowan, D.A., Ramond, J-B., Makhalanyane, T.P., De Maayer, P. 2015. Metagenomics of extreme environments. Current Opinion in Microbiology 25, pp97-102. doi:10.1016/j.mib.2015.05.005
 Draft genome sequence of thermophilic Geobacillus strain Sah69, isolated from Saharan soil, South-East Algeria.
Draft genome sequence of thermophilic Geobacillus strain Sah69, isolated from Saharan soil, South-East Algeria.
Bezuidt, O.K.I., Makhalanyane, T.P., Gomri, M.A., Kharroub, K., Cowan, D.A. 2015. Draft Genome Sequence of Thermophilic Geobacillus sp. Strain Sah69, Isolated from Saharan Soil, Southeast Algeria. Genome Announcements 3:10.1128/genomea.01447-15. doi:10.1128/genomea.01447-15
 Draft genome sequence of Williamsia strain D3, isolated from the Darwin Mountains, Antarctica.
Draft genome sequence of Williamsia strain D3, isolated from the Darwin Mountains, Antarctica.
Guerrero L.D., Makhalanyane T.P., Aislabie, J.M., Cowan, D.A. 2014. Draft genome sequence of Williamsia strain D3, isolated from the Darwin Mountains, Antarctica. Genome Announcements 2(1): e01230-13. doi:10.1128/genomeA.01230-13.
 Microbial Ecology and biogeochemistry of continental Antarctic soils.
Microbial Ecology and biogeochemistry of continental Antarctic soils.
Cowan, D.A., Makhalanyane, T.P., Dennis, P.G., and D.W, Hopkins. 2014. Microbial Ecology and biogeochemistry of continental Antarctic soils. Frontiers in Microbiology 5:154. doi:10.3389/fmicb.2014.00154.
 Draft genome sequence of the aromatic hydrocarbon-degrading bacterium Sphingobium strain Ant17 isolated from Antarctic soil.
Draft genome sequence of the aromatic hydrocarbon-degrading bacterium Sphingobium strain Ant17 isolated from Antarctic soil.
Adriaenssens, E.M. Guerrero, LD, Makhalanyane, T.P., Aislabie, J.M., Cowan D.A. 2014. Draft genome sequence of the aromatic hydrocarbon-degrading bacterium Sphingobium strain Ant17 isolated from Antarctic soil. Genome Announcements 2(2): e00212-14. doi: 10.1128/genomea.00212-14
 The draft genome sequence of Microbacterium CH12i, isolated from shallow groundwater in Cape Hallet, Antarctica.
The draft genome sequence of Microbacterium CH12i, isolated from shallow groundwater in Cape Hallet, Antarctica.
Ferreras, E.R., De Maayer, P., Makhalanyane, T.P., Guerrero, L.D., Aislabie, J.M. Cowan, D.A. 2014. The draft genome sequence of Microbacterium CH12i, isolated from shallow groundwater in Cape Hallet, Antarctica. Genome Announcements 2(4): e00789-14. doi:10.1128/genomeA.00789-14.
 Contrasting assembly processes in a bacterial metacommunity along a desiccation gradient.
Contrasting assembly processes in a bacterial metacommunity along a desiccation gradient.
Valverde, A., Makhalanyane, T.P., Cowan, DA. 2014. Contrasting assembly processes in a bacterial metacommunity along a desiccation gradient. Frontiers in Microbiology 5, pp 668. doi:10.3389/fmicb.2014.00668.
 Evidence of species recruitment and development of hot desert hypolithic communities.
Evidence of species recruitment and development of hot desert hypolithic communities.
Makhalanyane, T.P., Valverde, A., Lacap, D.C., Pointing, S.B., Tuffin, I.M., and D.A Cowan. 2013. Evidence of species recruitment and development of hot desert hypolithic communities. Environmental Microbiology Reports. 5 (2), pp 219-224. doi:10.1111/1758-2229.12003
 Evidence for successional development in Antarctic hypolithic bacterial communities.
Evidence for successional development in Antarctic hypolithic bacterial communities.
Makhalanyane, T.P., Valverde, A., Birkeland, N-K, Cary, S.C., Tuffin, I.M., and D.A. Cowan. 2013. Evidence for successional development in Antarctic hypolithic bacterial communities. The ISME Journal. 7, 2080-2090. doi:10.1038/ismej.2013.94.
 Abiotic drivers influence the microbial diversity in permanently cold soil horizons of a maritime-associated Antarctic Dry Valley.
Abiotic drivers influence the microbial diversity in permanently cold soil horizons of a maritime-associated Antarctic Dry Valley.
Stomeo, F., Makhalanyane T.P., Pointing, S.B., Stevens, M., Cary S.C., Tuffin, I.M., Cowan, D.A. 2012. Abiotic drivers influence the microbial diversity in permanently cold soil horizons of a maritime-associated Antarctic Dry Valley. FEMS Microbiology Ecology. 82 (2),pp 326-340. doi:10.1111/j.1574-6941.2012.01360.x
 Hypolithic communities: important nitrogen sources in Antarctic desert soils.
Hypolithic communities: important nitrogen sources in Antarctic desert soils.
Cowan, D.A., Sohm, J.A., Makhalanyane T.P., Capone, D.G, Green, T.G.A., Cary S.C and I.M Tuffin. 2011. Hypolithic communities: important nitrogen sources in Antarctic desert soils. Environmental Microbiology Reports, 3, pp 581-586. doi:10.1111/j.1758-2229.2011.00266.x
 Leveraging marine biotechnology for an All-Atlantic sustainable blue economy.
Leveraging marine biotechnology for an All-Atlantic sustainable blue economy. Hotspots of biogeochemical activity controlled by aridity and plant traits across global drylands.
Hotspots of biogeochemical activity controlled by aridity and plant traits across global drylands. A global atlas of soil viruses reveals unexplored biodiversity and potential biogeochemical impacts.
A global atlas of soil viruses reveals unexplored biodiversity and potential biogeochemical impacts. Harnessing Marine Microbiomes to Develop a Sustainable, All-Atlantic Bio economy.
Harnessing Marine Microbiomes to Develop a Sustainable, All-Atlantic Bio economy. Microbiome research in Africa must be based on equitable partnerships.
Microbiome research in Africa must be based on equitable partnerships.  Unearthing the soil-borne microbiome of land plants.
Unearthing the soil-borne microbiome of land plants.
 Vulnerability of mineral-protected soil organic carbon to climate in global drylands.
Vulnerability of mineral-protected soil organic carbon to climate in global drylands. Clarifying the healthy microbiome concept through an epidemiological lens.
Clarifying the healthy microbiome concept through an epidemiological lens.
 Soil biodiversity supports the delivery of multiple ecosystem functions in urban greenspaces.
Soil biodiversity supports the delivery of multiple ecosystem functions in urban greenspaces.
 The use of different 16S rRNA gene variable regions in biogeographical studies.
The use of different 16S rRNA gene variable regions in biogeographical studies.







 Microbial ecology of the Southern Ocean.
Microbial ecology of the Southern Ocean. Dysbiosis and immune dysregulation: distilling the evidence.
Dysbiosis and immune dysregulation: distilling the evidence. 
 Grazing and ecosystem service delivery in global drylands.
Grazing and ecosystem service delivery in global drylands.
 Dissolved inorganic carbon offsets salinity constraints on primary production in lakes.
Dissolved inorganic carbon offsets salinity constraints on primary production in lakes.
 Islands in the sand: Are all hypolithic microbial communities the same?
Islands in the sand: Are all hypolithic microbial communities the same?
 Global homogenization of the structure and function in the soil microbiome of urban greenspaces.
Global homogenization of the structure and function in the soil microbiome of urban greenspaces.  Long-read metagenomics of soil communities reveals phylum-specific secondary metabolite dynamics.
Long-read metagenomics of soil communities reveals phylum-specific secondary metabolite dynamics. 


 Microbial nitrogen cycling in Antarctic soils.
Microbial nitrogen cycling in Antarctic soils.
 The Agulhas current shapes microbial diversity and functionality.
The Agulhas current shapes microbial diversity and functionality.

 Assembling metagenomes, one community at a time.
Assembling metagenomes, one community at a time. Evidence of microbial rhodopsins in Antarctic Dry Valley edaphic systems.
Evidence of microbial rhodopsins in Antarctic Dry Valley edaphic systems.





 Cyanobacteria drive community composition and functionality in rock-soil interface communities.
Cyanobacteria drive community composition and functionality in rock-soil interface communities.

 Draft genome sequence of Williamsia strain D3, isolated from the Darwin Mountains, Antarctica.
Draft genome sequence of Williamsia strain D3, isolated from the Darwin Mountains, Antarctica.


 Evidence for successional development in Antarctic hypolithic bacterial communities.
Evidence for successional development in Antarctic hypolithic bacterial communities. 



 A concept for international societally relevant microbiology education and microbiology knowledge promulgation in society.
A concept for international societally relevant microbiology education and microbiology knowledge promulgation in society.




 Microbial anhydrobiosis.
Microbial anhydrobiosis.  Multiple energy sources and metabolic strategies sustain microbial diversity in Antarctic desert soils.
Multiple energy sources and metabolic strategies sustain microbial diversity in Antarctic desert soils. 
 Energy from thin air.
Energy from thin air. Metagenomic analysis provides insights into functional capacity in a hyperarid desert soil niche community.
Metagenomic analysis provides insights into functional capacity in a hyperarid desert soil niche community. Characterization of bacterial communities in lithobionts and soil niches from Victoria Valley, Antarctica.
Characterization of bacterial communities in lithobionts and soil niches from Victoria Valley, Antarctica. Comparative metagenomic analysis reveals mechanisms for stress response in hypoliths from extreme hyperarid deserts.
Comparative metagenomic analysis reveals mechanisms for stress response in hypoliths from extreme hyperarid deserts.  Antarctic microbial communities are functionally redundant, resistant and resilient to short term temperature perturbations.
Antarctic microbial communities are functionally redundant, resistant and resilient to short term temperature perturbations. Normalization of environmental metagenomic DNA enhances the discovery of under-represented microbial community members.
Normalization of environmental metagenomic DNA enhances the discovery of under-represented microbial community members. Ecology and biogeochemistry of cyanobacteria in soils, permafrost, aquatic and cryptic polar habitats.
Ecology and biogeochemistry of cyanobacteria in soils, permafrost, aquatic and cryptic polar habitats.  Abiotic drivers influence the microbial diversity in permanently cold soil horizons of a maritime-associated Antarctic Dry Valley.
Abiotic drivers influence the microbial diversity in permanently cold soil horizons of a maritime-associated Antarctic Dry Valley.